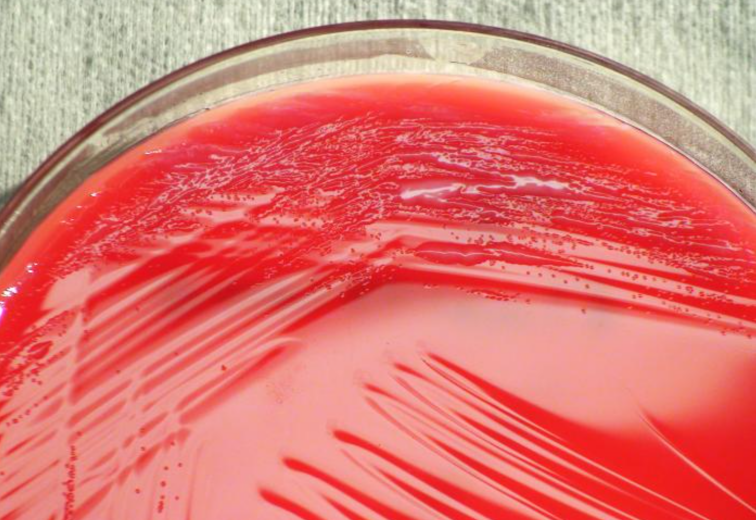

1.荧光假单胞菌(Pseudomonas fluorescens)
物种名:荧光假单胞菌
拉丁学名:Pseudomonas fluorescens
分类学地位:细菌界Bacteria;变形菌门Proteobacteria;
γ-变形菌纲Gammaproteobacteria;假单胞菌目Pseudomonadales;
假单胞菌科Pseudomonadaceae;假单胞菌属Pseudomonas
荧光假单胞菌(Pseudomonas fluorescens)是一种革兰氏阴性杆菌,以不产绿脓素而产荧光素而得名。是一种环境污染菌。对人类是少见机会病原菌,可从伤口、痰、胸水、尿和血液中分离出,亦可从血库血中分离。可在冰箱储存的血液及血液制品中繁殖,而且自溶后释放内毒素。
1.1生物学特性
1.1.1培养特征
荧光假单胞菌专性需氧,营养要求不高,在普通培养基上可生长,在营养琼脂平板上可形成荧光色的菌落,约94%的菌株产生水溶性荧光素(青脓素),在紫外线(360 nm)照射下呈黄绿色荧光,有些菌株产生蓝色色素,不扩散。在血琼脂平板上32℃培养18-24 h,形成圆形、扁平稍隆起、光滑、湿润、暗灰白色或灰绿色的菌落(图1)[1]。
图1 荧光假单胞菌在血平板上的培养结果[2]
1.1.2形态学特征
革兰氏阴性杆菌,大小一般为(0.7-0.8) μm×(2.3-2.8) μm,呈单个或成对排列,具有极生鞭毛,偶见无鞭毛无动力的菌株,运动活泼,不形成芽孢[1]。

图2 荧光假单胞菌扫描电镜照片[3]
1.1.3生化特征
本菌能液化明胶,葡萄糖发酵、蔗糖发酵、乳糖发酵均为阳性,并且能以多种醇类物质作为碳源,不能利用乙醇、L-鼠李糖等。甲基红试验、柠檬酸盐发酵、接触酶反应均为阳性,水解淀粉、脂酶反应阴性[1]。
1.1.4分子生物学特征
目前,两种荧光假单胞菌菌株的基因组已完全测序。荧光假单胞菌Pf-5基因组包含一条环状染色体,GC含量为63.3%。它包含87个RNA和6137个蛋白质;荧光假单胞菌PfO-1的基因组有一条染色体,其GC含量为60.5%,有95种RNA和5736种蛋白质[4]。
1.2分布、传播与致病性
1.2.1分布与传播
荧光假单胞菌广泛分布于水、土壤及正常人体皮肤等部位,在海洋环境中也普遍存在,常与食物(鸡蛋、血、牛乳等)腐败有关,可作为咽部的正常菌群存在,是人类少见的条件致病菌,偶从泌尿道感染病人尿中分离出,感染该菌可引起菌血症、泌尿道感染等疾病。由于具有嗜冷性,可在冰箱储存血液中繁殖,若输入含有此菌的血库血液,可导致病人不可逆性的休克而死亡。
1.2.2致病性
荧光假单胞菌的致病因素是其所释放的内毒素。内毒素的磷脂成分可引起细菌性休克以及弥漫性血管内凝血,它能导致先天性或者获得性免疫缺陷症的病人罹患骨髓炎、败血症、化脓性关节炎、泌尿道及肺部感染等多种疾病。此外,荧光假单胞菌也是水生经济动物的条件致病菌,可引发草鱼、青鱼、鲤鱼、鲫鱼等大多数淡水鱼类的赤皮病,也能引起热带鱼、鲑科鱼类和多种鱼类的细菌性败血病和赤皮病[5]。
人类因感染荧光假单胞菌而患病的主要途径是食用受该菌污染的食品或水。荧光假单胞菌常存在于低温环境中,如冰箱中的牛奶等乳制品,虽然通常巴氏杀菌工艺(72℃, 15 s)可以将荧光假单胞菌杀死,但是荧光假单胞菌分泌的胞外耐热性蛋白酶可以耐受超高温瞬时灭菌(137℃, 4 s)而存活,通常情况下大约会有10%的残留[6]。
荧光假单胞菌对阿米卡星、庆大霉素、妥布霉素、奈替霉素、哌拉西林、替卡西林、拉莫塞夫和头孢他啶敏感,可采用多种抗生素进行联合治疗。
1.3检测方法
(1)传统方法:检验该菌时,可取样品接种于普通平板或者血平板中,分离培养的温度应在22-25℃,以免出现假阴性。该菌的鉴定可根据下述最低鉴定特征进行诊断:①革兰氏阴性单端丛毛菌,运动活泼;②氧化分解葡萄糖,多数菌株不分解乳糖、蔗糖;③氧化酶试验阳性;④产生荧光素,不产生绿脓素;⑤42℃不生长;⑥精氨酸双水解酶阳性;⑦产生卵磷脂酶,能液化明胶(此试验可与产生荧光素的恶臭假单胞菌相鉴别)[7]。
(2)分子生物学方法:胡冰雪等利用荧光假单胞菌的gyrB基因,采用多重PCR(m-PCR)方法对荧光假单胞菌进行鉴定,该方法的检测限可达到9 CFU/mL。
具体引物序列如下表[8]:
表1 荧光假单胞菌m-PCR引物序列
| 名称 | 序列 | 产物大小(bp) |
| gvrB-F | 5′-TGCGGTCAACCAGGTGTTCC-3′ | 20 |
| gvrB-R | 5′-CGAGATAATCGCGGTCAGG-3′ | 19 |
1.4典型案例
Feazel[9]等采集了来自美国45个淋浴喷头及流入淋浴喷头的水的样品,鉴定淋浴喷头生物膜的微生物成分,发现在淋浴喷头中除了有鸟分枝杆菌和嗜肺军团菌等常见的致病菌外,还检测到了荧光假单胞菌、金黄色葡萄球菌等其他菌种。
目前我国有关荧光假单胞菌污染的著名事件是“发光猪肉”,湖南某一市民从市场买回猪肉发现在夜晚猪肉会发出幽幽的蓝光,事件一经报道便引起了恐慌。专家调查后对猪肉进行了微生物检测,发现正是荧光假单胞菌污染产生的荧光素使猪肉发出荧光[10]。
1.5防治对策
荧光假单胞菌作为一种环境污染菌,日常生活中要注意冰箱中保存的饮用水、乳制品、蛋类等是否受污染;在临床床上,要注意血液及血制品被荧光假单胞菌污染。若感染该菌可用荧光假单胞菌对阿米卡星、庆大霉素、妥布霉素进行治疗。
参考文献
[1] 周庭银. 临床微生物学诊断与图解 第3版. 上海: 上海科学技术出版社, 2012.
[2] https://phil.cdc.gov/Details.aspx?pid=12458.
[3] Scales BS, Dickson RP, LiPuma JJ et al. Microbiology, genomics, and clinical significance of the Pseudomonas fluorescens species complex, an unappreciated colonizer of humans. Clin Microbiol Rev, 2014, 27: 927-948.
[4] http://www.ncbi.nlm.nih.gov/entrez/query.fcgi?db=genomeprj&cmd=Retrieve&dopt=Overview&list_uids=12300.
[5] Swain P, Behura A, Dash S et al. Serum antibody response of Indian major carp, Labeo rohita to three species of pathogenic bacteria; Aeromonas hydrophila, Edwardsiella tarda and Pseudomonas fluorescens. Vet Immunol Immunopathol, 2007, 117: 137-141.
[6] 高琳, 陈万义, 任婧. 食品中荧光假单胞菌的危害及其快速检测方法研究进展. 食品工业科技, 2015, 36: 373-377.
[7] 李振林. 微生物学及检验技术. 广州: 广东科技出版社, 1997.
[8] 胡冰雪, 舒沿沿, 潘道东 等. 荧光假单胞菌、沙门氏菌和单增李斯特菌多重PCR检测方法的建立. 食品科学, 2016, 37: 209-214.
[9] Feazel LM, Baumgartner LK, Peterson KL et al. Opportunistic pathogens enriched in showerhead biofilms. Proc Natl Acad Sci U S A, 2009, 106: 16393-16399.
[10] https://news.foodmate.net/2011/12/196335.html.
.png)
